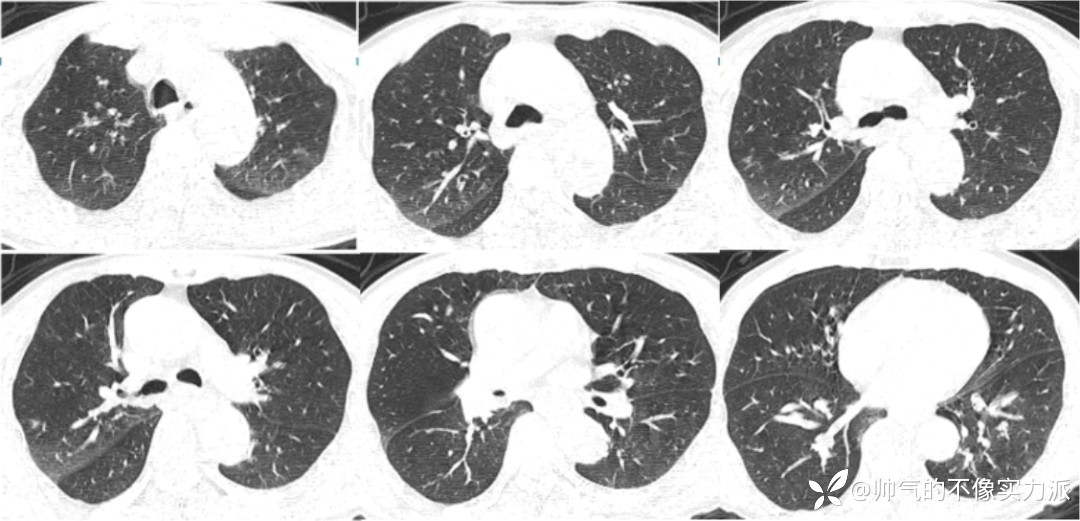
img

意识障碍12小时入院,4天后加重入呼吸ICU,究竟是哪个惹的祸?
离床医学离床医学 推荐意识障碍12小时入院,4天后加重入呼吸ICU,究竟是哪个惹的祸?
本例为64岁老年男性患者,因“意识障碍12 h”入院,经积极抗感染、大量补液、促醒等对症治疗后,患者意识反应稍有好转。入院4天后,因肺部感染加重且合并肺栓塞转入呼吸ICU。究竟是什么原因导致患者病情恶化?治疗团队又采取了哪些救治措施?
病例介绍
一般情况
患者,男性,64岁。因“意识障碍12 h”于2020年12月8日入我院神经重症病区治疗。
现病史
入院前12小时前饮500 ml红酒后出现意识障碍,呼之不应,四肢无力,伴呕吐,为胃内容物,后家属发现患者有呼吸暂停,至我院急诊。查头颅及胸部CT:双侧基底节区腔梗灶,右肺上叶、左肺下叶胸膜下小结节,双肺少许炎症。给予促醒及补液治疗,患者有自发眨眼及撅嘴动作,呼唤仍不睁眼,刺激肢体无活动,为求进一步治疗收入我科。自发病来意识如上述,未进食,大便未解,留置导尿管。
既往史及其他
无高血压、心脏病、糖尿病、脑血管疾病病史,饮酒40年,近10年每日均有饮酒,约3斤啤酒或半瓶红酒,无吸烟史。婚姻史、家族史无特殊。
入神经重症科体格检查
T 36.2℃,P 105次/min,R 20次/min,BP 89/56 mmHg。颈软,无抵抗,肺部听诊未闻及干、湿啰音,心脏听诊未闻及异常杂音,腹部柔软,肠鸣音正常。神经系统查体:浅昏迷,双瞳孔等大等圆,直径2 mm,对光反射灵敏,压眶刺激面部有痛苦表情,双侧额纹、鼻唇沟基本对称,余颅神经查体欠配合。刺激四肢未见肌肉收缩,肌张力低,四肢腱反射未引出,双侧病理征阴性。
急诊胸部CT
2020年12月7日,急诊胸部CT提示肺部慢性炎症,右肺小结节影(图1)。

图1 患者胸部CT(2020-12-07)
头颅MRI+MRA+MRV
2020年12月7日,头颅MRI+MRA+MRV示:①右侧额叶、双侧基底节区、右侧侧脑室旁、双侧丘脑、桥脑、右侧小脑半球陈旧性病变;②双侧额颞顶叶、双侧侧脑室旁白质脱髓鞘;③双侧筛窦炎脑;④MRA提示左侧大脑后动脉P2段局限性狭窄;轻度脑动脉硬化改变;⑤脑MRV未见明显异常。
入院初步诊断
(1)意识障碍查因:急性酒精中毒?感染中毒性脑病?
(2)感染性休克?
(3)肺部感染。
(4)肺结节。
(5)右肾结石。
初始治疗
- 抗感染:美洛西林舒巴坦+喷昔洛韦。
- 补液。
- 促醒、营养神经。
- 营养支持。
- 急请血液净化中心会诊,考虑患者酒精中毒诊断不甚明确,且急性酒精中毒后最佳透析时间为6 h内。入院后患者已过最佳透析时间,且患者经积极大量补液、促醒等对症治疗,意识反应较前稍有好转,故未行透析治疗。
入院后辅助检查
- 动脉血气分析(鼻导管吸氧3 L/min):Lac 4.8 mmol/L,pH 7.31,PaO2 62 mmHg,PaCO2 43 mmHg,HCO3- 21.7 mmol/L,BE -4.5 mmol/L。氧合指数186 mmHg。
- 血常规:WBC 6.79×109/L,Hb 143.6 g/L,PLT 234×109/L。NEU% 66.6%,LYM绝对值0.62×109/L。
- 尿常规:酮体(+),隐血(+++)。
- 生化:K+ 3.46 mmol/L,Ca2+ 1.82 mmol/L,白蛋白33.5 g/L。肌酸激酶、肌酸激酶同工酶、乳酸脱氢酶均正常。
- 感染及炎症指标:CRP 129 mg/L,ESR 4 mm/h,PCT 4.7 ng/ml。T-SPOT(-)。G、GM试验均正常。
- 血凝试验:PT 9.90 s,PT活动度118,INR 0.90,APTT 24.00 s,FIB 1.64 g/L,TT 16.00 s。D-D 0.66 mg/L。
- 病毒:EB病毒IgG(+),巨细胞病毒IgG(+),二者DNA定量均正常。其余均为阴性。
- 结缔组织病全套及类风湿因子:均为阴性。
- 淋巴细胞亚群:CD3+CD4+计数明显下降(139.62个/μl)。
- 肿瘤标志物:非小细胞肺癌抗原21-1 4.64 ng/ml,游离前列腺特异抗原0.52 ng/ml。
- 脑脊液:压力100 cmH2O,细胞学检查正常。脑脊液病毒检测均为阴性。
- 心电图:窦性心动过速。
- 床旁彩超(2020-12-09):主动脉窦部增宽,左室舒张功能下降,射血分数约为60%。肝、胆、胰、脾、肾、输尿管均未见明显异常,甲状腺及甲状旁腺区未见明显异常,双侧颈动脉、椎动脉及锁骨下动脉均未见明显异常,下腔静脉生理搏动减弱。右侧股总静脉置管术后,置管周围血栓形成。
病情变化
- 2020年12月9日01:45,患者出现氧饱和度下降,呼吸困难,考虑存在误吸,给予经口气管插管治疗。
- 与入院前胸部CT相比,患者上肺结节斑片及磨玻璃样渗出影,双侧下肺重力依赖区明显实变影,出现支气管充气征(图2)。


图2 患者胸部CT(2020-12-09)
调整治疗
- 抗感染:亚胺培南西司他丁钠+利奈唑胺+喷昔洛韦。
- 促醒、营养神经。
- 保护胃黏膜。
- 营养支持。
- 脑脊液常规生化细胞学结果不支持颅内感染存在。
进一步检查
- 2020年12月9日,患者机械通气模式为SIMV+容控,P 15 cmH2O,FiO2 70%,Vt 460 ml,PEEP 5 cmH2O。T 37.2℃,P 118次/min,R 28次/min,BP 104/68 mmHg。双肺可闻及湿啰音。虽经积极的液体复苏,仍需血管活性药物(去甲肾上腺素)维持血压。12月10—12日,患者PCT水平呈下降趋势。
- 血气分析:Lac 2.7 mmol/L,pH 7.31,PaO2 75 mmHg,PaCO2 57 mmHg,HCO3- 28.7 mmol/L。
- 考虑患者有无肺栓塞可能?故进一步完善CT肺动脉造影(CTPA)检查,结果提示右肺下叶动脉内低密度充盈缺损,考虑栓子形成可能。双肺炎症并部分肺实变,建议治疗后复查。
- 患者影像学提示疾病进展快,进一步完善BALF mNGS检查。
- 2020年12月12日,复查胸部CT:双上肺磨玻璃影明显增多,下肺重力依赖区依然存在实变影,少量胸腔积液(图3)。


图3 患者胸部CT(2020-12-12)
2020年12月12日转入我科
- 患者意识状况较前稍有好转,但感染指标仍较高,肺部感染较重,合并肺栓塞。
- 转入查体:意识模糊,呼唤后可睁眼,能部分配合指令性动作,经口气管插管有创呼吸机辅助呼吸(模式:PS/CPAP),PEEP 5 cmH2O,心电监护心率104次/min,呼吸22次/min,血压133/70 mmHg(使用升压药物),氧饱和度为96%,双肺听诊呼吸音粗、湿啰音。心率104次/min,律齐,各瓣膜听诊区未闻及明显杂音。
- 诊断:吸入性肺炎;脓毒症休克;肺栓塞;胸腔积液;意识障碍查因:急性酒精中毒?感染中毒性脑病?
转入后相关检查
- 有创通气(PS/CPAP),FiO2 50%,PEEP 5 cmH2O,PC 16 cmH2O。pH 7.468,PaO2 74.1 mmHg,PaCO2 39.7 mmHg。氧合指数148 mmHg。
- BALF mNGS回报流感嗜血杆菌、肺炎克雷伯菌、金黄色葡萄球菌、幽门螺杆菌。
- 血常规:PLT 89×109/L,LYM绝对值0.43×109/L,WBC 6.29×109/L,Hb 99 g/L,NEU% 85%。
- 生化:Na+ 134 mmol/L,Ca2+ 2.19 mmol/L,白蛋白29.7 g/L,总蛋白56.4 g/L,ALT 99 U/L,AST 169 U/L,γ-GT 188 U/L,ALP 227 U/L。
- 痰培养(2020-12-12):金黄色葡萄球菌(MRSA)。
- 床旁电子气管镜:气道黏膜充血水肿,有血性分泌物(图4)。

图4 床旁电子气管镜检查
转入后诊断
- 吸入性肺炎,ARDS。
- 毒症休克。
- 肺栓塞。
- 双侧胸腔积液。
- 意识障碍查因:急性酒精中毒?感染中毒性脑病?
- 贫血、血小板降低。
- 低蛋白血症。
调整治疗方案
- 抗感染:患者转入ICU后,体温最高达到39℃,肺部病变进展快速,且考虑患者长期在海南生活,不排除重症军团菌感染的可能,选择哌拉西林他唑巴坦(4.5 g q8h)+莫西沙星(0.4 g qd);结合痰培养结果,加入替考拉宁(0.4 g qd);根据气管镜检查结果,不能排除真菌感染,故加用两性霉素B雾化。
- 抗炎:甲强龙40 mg qd,3 d。
- 呼吸支持:与家属沟通后行间断俯卧位通气;第一次行俯卧位通气时气管插管意外脱出,监测患者血气后,改为HFNC。
- 其他:低分子肝素4100 IU q12h;人免疫球蛋白针10 g。
相关检查
- 呼吸ICU送检2次BALF培养,结果回报鲍曼不动杆菌和肺炎克雷伯菌,且肺炎克雷伯菌对复方新诺明、替加环素、多西环素、多黏菌素敏感。
- 复查胸部CT(2020-12-16):双上肺病变仍然较重,双下肺重力依赖区实变影明显吸收,双侧少量胸腔积液(图5)。


图5 患者胸部CT(2020-12-16)
- 复查床旁电子气管镜(2020-12-17):气道糜烂及血性分泌物较前好转(图6)。

图6 床旁电子气管镜检查(2020-12-17)
治疗效果及患者转归
- 患者体温逐步趋于稳定,甲强龙剂量逐渐减量(20 mg qd,5 d→10 mg qd,3 d)。
- 2020年12月23日复查胸部CT:双上肺病变明显吸收,遗留少量斑片条索影,双下肺吸收良好(图7)。

图7 患者胸部CT(2020-12-23)
- 12月20日,患者体温波动(低于38℃)。12月22日,体温恢复正常。12月25日,患者转至我院干部病房继续治疗。抗感染药物为头孢吡肟(2.0 g q8h)+多西环素(0.2 g qd)。
- 意识状态变化:12月8日昏迷;12月9日,嗜睡,呼唤可睁眼;12月15日,谵妄——精神科会诊考虑戒断综合征,给予奥氮平后逐渐好转;12月19日,神志清。
- 12月29日,患者出院。
治疗体会
回顾患者治疗经过(图8),有如下体会:
- 应提高对吸入性肺炎的认识。
- ARDS患者俯卧位通气很重要。
- 对mNGS结果判读需要结合临床。

图8 患者治疗经过
















































